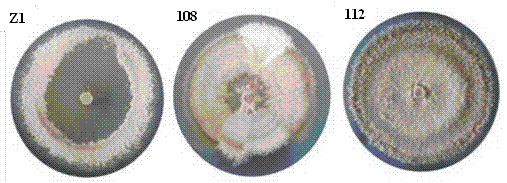

Introducción
El café (Coffea arabica) se cultiva en más de 80 países de América Latina, África y Asia (Coutiño et al., 2017). En México se introdujo alrededor de 1790 (Medina-Meléndez et al., 2016), convirtiéndose en una actividad de gran relevancia en términos de producción, valor comercial, económico y social (Santiago-Santiago, 2020). Oaxaca es uno de los principales estados productores de café y pionero en la producción de café orgánico (Valkila, 2009); por lo que la aplicación de bioinoculantes con propiedades de control biológico es una de las máximas prioridades en la producción agrícola limpia y sostenible (Vu y Tran, 2020).
Trichoderma es un hongo cosmopolita (Herrera-Parra et al., 2017), incluye más de 100 especies (Savín-Molina et al., 2021) y algunas de ellas se han estudiado para su uso como agentes de control biológico (BCA) contra patógenos de plantas (Kannangara y Dharmarathna, 2017), incluyendo contra Hemileia vastatrix, causante de la roya del cafeto (Gomez-De La Cruz et al., 2017). La importancia de este género radica en que algunas especies colonizan las raíces (Contreras-Cornejo et al., 2009), donde compiten por espacio y nutrientes (Savín-Molina et al., 2021), promueven el crecimiento de las plantas e inducen resistencia sistémica (Andrade-Hoyos et al., 2019); además, producen metabolitos secundarios que protegen las plantas contra hongos fitopatógenos a través de mecanismos que incluyen antibiosis y micoparasitismo (Yassin et al., 2022). Por otro lado, la antracnosis, causada por Colletotrichum spp., es una de las enfermedades más comunes e importantes en el cultivo de café, debido a que causa pérdidas económicas importantes (Luo et al., 2015).
A pesar de que Trichoderma se ha evaluado durante más de 70 años como antagonista, su comercialización como biocontrolador agrícola se inició a principios del siglo XXI (Pineda-Insuasti et al., 2017). Existen estudios donde se ha utilizado como antagonista ante Colletotrichum en diferentes cultivos de interés económico como maracuyá (Passiflora edulis) (Niño y Mogollón, 2018), mango (Mangifera indica) (Díaz-Medina et al., 2019), fresa (Fragaria × ananassa) (Morales-Mora et al., 2020), entre otros. Sin embargo, existen pocos estudios sobre el efecto antagonista de Trichoderma ante Colletotrichum en plantaciones de café. Por otro lado, Arias-Mota y Heredia-Abarca (2022), menciona que Trichoderma es una opción de control biológico amigable con el ambiente, además de contribuir al mantenimiento de cultivos orgánicos. Por lo que el objetivo del estudio fue caracterizar cepas de Trichoderma spp. nativas de Oaxaca y evaluar su potencial de biocontrol contra Colletotrichum spp., agente causal de la antracnosis en plantas de café.
Materiales y Métodos
Obtención de aislamientos de Colletotrichum y Trichoderma. Muestras de suelo se colectaron de parcelas de café arábico con manejo orgánico en los municipios San Bartolomé Loxicha, San Agustín Loxicha y Aguacate Loxicha del estado de Oaxaca. Los muestreos se realizaron mediante la metodología cinco de oros para completar una muestra compuesta de 100 g de suelo por sitio de estudio (un sitio por municipio). En laboratorio, las muestras se procesaron por el método de dilución de suelo en cajas Petri siguiendo la metodología de Waksman (1927). A partir de una solución madre (10 mL
agua destilada estéril: 1 g suelo) se obtuvo la dilución de 10-2, de la cual se tomó una alícuota de 0.1 mL y se esparció uniformemente sobre cajas Petri con Papa Dextrosa Agar (PDA). Las placas se incubaron a temperatura ambiente (25 °C) por 72 h y posteriormente, se cuantificó el número de colonias fúngicas formadas (15). De cada una de las placas se aislaron colonias fúngicas (12) individuales para observar su morfología colonial y formación de estructuras reproductivas, las cuales permitieron identificar a nivel género (Barnett y Hunter, 1998). Los aislamientos con morfología similar a Trichoderma se purificaron por punta de hifa en PDA. Finalmente, los aislamientos, se conservaron en glicerol hasta su proceso de reactivación.
En forma paralela, en plantaciones comerciales de café arábico orgánico en Oaxaca (Municipio de San Agustín Loxicha) y Chiapas (Municipio de Unión Juárez), se colectaron frutos y hojas de café arábico variedad Bourbon con síntomas de antracnosis los cuales mostraban necrosis en sus tejidos. En laboratorio se cortaron dos fragmentos (1 cm2) del tejido enfermo de cada muestra, se esterilizaron con NaOCl al 1.5% durante 1 min, posteriormente se hizo triple lavado en agua destilada estéril y finalmente se secó en papel estéril. Los tejidos se incubaron en PDA a 25 °C durante 48 h; las colonias fúngicas desarrolladas se trasfirieron a nuevas placas de PDA para generar estructuras de reproducción que permitieron la identificación a género (Cao et al., 2019; Hassan et al., 2018; Cristóbal-Martínez et al., 2017). Del total de aislamientos obtenidos (11), para fines del presente estudio se seleccionaron (tres) aquellos aislamientos con morfología similar a Colletotrichum y que mostraron mayor tasa de crecimiento y mayor producción de conidios producidos por área de crecimiento miceliar.
Caracterización macroscópica. Los aislamientos fúngicos seleccionados se reactivaron en PDA; luego de un periodo de incubación (siete días), se utilizaron para describir la morfología colonial externa. Se consideraron características como: textura (algodonoso, plano) y color del micelio (blanco, verde), formación de anillos concéntricos (presencia, ausencia) (Granda-Mora et al., 2020; García-Núñez et al., 2017) y el color al reverso de las colonias (hialino, amarillo, café) (López-Calva et al., 2018).
Caracterización microscópica. A partir de los aislamientos seleccionados tanto de Trichoderma como Colletotrichum, se realizaron preparaciones temporales con base glicerol y con un microscopio compuesto (Velab, modelo Ve-b2) a 40x y cámara digital (QUASAR) acoplada al microscopio, se fotografiaron esporas de cada uno de los aislamientos.
Para la observación de las fiálides de Trichoderma, se realizaron microcultivos de acuerdo con el método de Vu y Tran (2020); para ello, en condiciones asépticas, sobre un portaobjetos estéril se colocó un disco (5 mm de diámetro) de PDA y con una aguja entomológica se tomaron masas de conidias de las colonias purificadas y se depositaron sobre el portaobjetos; posteriormente se colocó un cubreobjetos estéril y la preparación se colocó dentro de una placa Petri que contenía papel estéril húmedo. Las muestras se incubaron durante 4 a 5 días a 25 °C. Posteriormente, se observaron al microscopio y se tomaron fotografías, con el fin de observar la forma de las estructuras. Para determinar el tamaño, con el programa AmScope se tomaron fotografías de grupos de conidias por cada aislamiento y de ellos se midió el largo y ancho de 100 conidias; finalmente se obtuvo el promedio de la población evaluada.
Tasa de crecimiento (TC). De cada aislamiento se tomó un disco de crecimiento miceliar (5 mm de diámetro) y se transfirió al centro de una nueva caja Petri con PDA; posteriormente se incubaron a 25 °C y se tomaron medidas diametrales cada 24 h hasta que el micelio cubriera por completo la superficie de la caja. Al finalizar el experimento se calculó la TC utilizando la fórmula de Zadoks y Schein (1979).
Dónde: Cf= Crecimiento diametral final (mm); Ci= Crecimiento diametral inicial (mm); Tf= Tiempo final (días); Ti= Tiempo inicial (día uno).
Identificación molecular. Los aislamientos seleccionados se cultivaron en un medio líquido de papa sacarosa durante 7 días a temperatura ambiente (25 °C) y agitación continua. El ADN se extrajo del micelio de cada uno de los aislamientos, utilizando 1 g de micelio de acuerdo a la metodología modificada de Castle et al. (1998). La integridad del ADN extraído se determinó mediante electroforesis en gel de agarosa al 1%.
La mezcla de reacción de PCR se realizó en un volumen final de 25 μL, la cual contenía 50 pM del ADN genómico, 10X Buffer, 2 mM MgCl2, 0.2 mM del mix dNTPs,
1 U de la enzima Taq DNA polimerasa y 50 pM de los iniciadores ITS1 (5′- TCCGTAGGTGAACCTGCG-3′) e ITS4 (5′-TCCTCCGCTTATTGATATGC-3′)
(Aljanabi y Martínez, 1997). El programa de amplificación, consistió en 1 ciclo de 94 °C por 6 min, 35 ciclos de 94 °C por 1 min, 55 °C por 1 min, 72 °C por 1 min y un ciclo de 72 °C por 7 min y se procedió a visualizarla en un gel de agarosa al 1.2 % en una cámara de electroforesis (Bio-Rad®) a 100 V por 30 min. La purificación de ADN amplificado se llevó a cabo con un kit comercial (ZymocleanTM), y la secuenciación se llevó a cabo siguiendo la metodología Sanger con la aplicación del kit BigDye® Terminator v3.1 Cycle Sequencing, en un secuenciador ABI 3130.
Reconstrucción filogenética. El análisis bioinformático de las secuencias se realizó con el software MEGA11 (Tamura et al., 2021) y se alinearon mediante el algoritmo de agrupación W. Las secuencias obtenidas se compararon con secuencias de otras especies de Trichoderma incluidas en el GenBank utilizando la herramienta básica de búsqueda BLAST (http://www.ncbi.nlm.nih.gov/BLAST), y las secuencias con mayor similitud se utilizaron para asignar la identificación de especie a cada cepa aislada. El árbol filogenético se ensambló empleando el método Bootstrap (1000 repeticiones), con secuencias obtenidas del GenBank y secuencias de identificación molecular referenciadas en el GeneBank de la base de datos del National Center Biotechnology Information (NCBI).
Pruebas de antagonismo. Para determinar la capacidad antagónica de los aislamientos, se realizaron pruebas de confrontamientos duales; para ello, se empleó un diseño completamente aleatorizado. Se utilizaron tres aislamientos de Trichoderma (T13, T14 y T15; con mayor TC y conidios observados), y tres aislamientos de Colletotrichum (112,108 y Z1), cada confrontamiento se repitió tres veces. En placas Petri de 90 mm de diámetro con PDA, se colocó un disco de 5 mm de diámetro de Trichoderma (previamente crecido en PDA por cinco días) en un extremo de la caja y en el extremo equidistante un disco de micelio (previamente crecido en PDA por cinco días) de 5 mm de diámetro con Colletotrichum, para ello se depositaron primero los discos de Colletotrichum y cuatro días después los de Trichoderma. Las cajas se incubaron a 25 °C y el crecimiento radial se registró cada 24 h para evaluar el porcentaje de inhibición del crecimiento micelial mediante la fórmula propuesta por Ezziyyani et al. (2007).
Dónde: PICR= porcentaje de inhibición de crecimiento radial; R1= crecimiento radial (mm) del patógeno sin Trichoderma spp. R2= crecimiento radial (mm) del hongo con Trichoderma spp.
Análisis estadístico. Los datos obtenidos para cada uno de los ensayos cumplieron los supuestos de normalidad y homogeneidad y se sometieron a un análisis de varianza y una prueba de comparación de medias Tukey (p≤ 0.05). Dichos datos se analizaron con el paquete estadístico SAS versión 9.0 para Windows. A excepción de la TC los datos obtenidos se transformaron a raíz cuadrada +1 para cumplir con los supuestos de normalidad y homogeneidad (Toutenburg y Shalabh, 2009), similar a lo realizado por Savín-Molina et al. (2021).
Resultados y Discusión
Caracterización macroscópica. Se caracterizaron 12 aislamientos de Trichoderma, de las cuales el 41.6% presentó una colonia color verde (T2, T6, T13, T14 y T15) y el 58.4% mostró tonalidad blanca (T3, T4, T5, T7, T9, T10 y T12); el 50% desarrolló micelio plano (T2, T5, T6 T13, T14 y T15) y el otro 50% micelio algodonoso (T3, T4, T7, T9, T10 y T12); el 50% no presentó anillos concéntricos (T2, T3, T4, T5, T9 y T10), el 8.4% un anillo concéntrico (T7), el 25% dos anillos concéntricos (T6, T12 y T13) y el 16.6% restante presentaron tres anillos (T14 y T15). Arias-Mota y Heredia-Abarca (2022) mencionan que de 438 especies de Trichoderma descritas a nivel mundial, 30 han sido registradas asociadas a plantas de café, todas con heterogeneidad en sus características morfológicas; por ello Hermosa et al. (2000) resalta la importancia de realizar estudios moleculares para tener un análisis con mayor certeza taxonómica. Las cepas T2, T4, T5, T6 y T12 presentaron micelio hialino (41.6%); las cepas T3, T7, T9 y T10 mostraron tonos de color amarillo (33.4%) y las cepas T13, T14 y T15 tuvieron tonalidades de color café (25%) (Figura 1). La coloración de los aislamientos puede estar influenciada por antraquinonas, los cuales son los pigmentos fúngicos naturales más abundantes que dan color a las estructuras de desarrollo (Yu y Keller 2005). La cepa T6 presentó aroma intenso a coco (8.4%) y puede estar asociada a la presencia de 6-penta-alfa-pirona, la cual ha sido reportada para T. harzianum (Rocha-Valdez et al., 2005). Con respecto a los aislamientos de Colletotrichum, los aislamientos Z1 y 112 presentaron colonia color blanco y el aislamiento 108 presentó color gris; todos los aislamientos presentaron forma circular; con respecto al micelio algodonoso se presentó en Z1 y 112; y plano en 108; la coloración del micelio fue blanco en Z1 y 112, y gris en 108 (Figura 2).
Caracterización microscópica. De los 12 aislamientos de Trichoderma, el 33.4% presentaron conidios de forma subglobosa (T2, T4, T7 y T12); 25% mostraron forma elipsoidal (T5, T6 y T9) y 25% conidios de forma globosa (T13. T14 y T15). El tamaño de los conidios osciló entre 7.91-10.21 µm de largo y de 6.65-7.83 µm de ancho (Cuadro 1). Todas las cepas produjeron cantidades similares de conidios, lo cual es atribuible a su desarrollo en condiciones ambientales homogéneas (Osorio-Concepción et al., 2013); sin embargo, existieron cepas que no produjeron conidios, esto puede deberse a su condición genética (Martínez et al., 2013). Harman (1990) menciona que los aislados pertenecientes a la misma especie difieren en la producción de estructuras fúngicas durante la multiplicación, incluso en el mismo medio de cultivo, lo que denotaría la presencia de diferentes subespecies o ecotipos. Los aislamientos obtenidos y seleccionados a partir de tejidos de café con síntomas de antracnosis, presentaron conidios de forma ovoide con un largo entre 10.3 - 13.3 µm y ancho entre 3.3 - 4.5 µm. Estas características, junto con las variables de tasa de crecimiento, color de colonia y forma de los apresorios, se utilizan para diferenciar especies de Colletotrichum (Hu et al., 2015; Hyde et al., 2009). Otro criterio utilizado para separar o agrupar posibles especies, se basa principalmente en su planta hospedera (Cano et al., 2004). Sin embargo, de 39 especies reportadas por Sutton (1992) dentro de este género, el autor señala que su separación o reconocimiento entre especies no es del todo claro, pero permite dar un acercamiento a su identificación.
Cuadro 1 Caracterización y tasa de crecimiento de los diferentes aislamientos de Trichoderma spp.
| Conidios | |||||||
|---|---|---|---|---|---|---|---|
| Cepaz | Forma | Largo (µm) | Ancho (µm) | Tasa de crecimiento | |||
| T. sulphureum (T4) | Subglobosa | 9.89 | 7.14 | 2.95 | ± | 0.09 | a |
| T. lentiforme (T15) | Globosa | 8.64 | 7.07 | 2.66 | ± | 0.38 | a |
| T. sulphureum (T5) | Elipsoidal | 9.93 | 7.51 | 2.60 | ± | 0.30 | a |
| T. spiralek (T3) | ND | ND | ND | 2.51 | ± | 0.06 | ab |
| T. harzianum (T7) | Subglobosa | 8.05 | 6.69 | 2.45 | ± | 0.06 | abc |
| T. lentiforme (T13) | Globosa | 7.91 | 6.71 | 2.31 | ± | 0.01 | abcd |
| T. lentiforme (T14) | Globosa | 8.22 | 6.92 | 2.30 | ± | 0.01 | abcd |
| T. koningii (T6) | Elipsoidal | 9.53 | 7.83 | 2.28 | ± | 0.06 | abcd |
| T. spirale (T9) | Elipsoidal | 10.22 | 6.66 | 2.23 | ± | 0.04 | abcd |
| T. pleuroticola (T2) | Subglobosa | 9.06 | 7.72 | 1.78 | ± | 0.01 | bcd |
| T. tomentosum (T12) | Subglobosa | 9.84 | 7.5 | 1.74 | ± | 0.01 | dc |
| T. spirale (T10) | ND | ND | ND | 1.69 | ± | 0.02 | dc |
zDeterminada por secuenciación de la región ITS del rDNA. ND. No determinada. Letras diferentes significa diferencia significativa entre tratamientos de acuerdo con la prueba de Tukey p≤0.05.
Tasa de crecimiento (TC). Dentro de los aislamientos correspondientes al género Trichoderma, los que mostraron mayor velocidad de crecimiento significativa fueron T4, T5 y T15 (Tukey, 0.05). El aislamiento T4 tuvo un mayor crecimiento diametral con 1.3 mm día-1 de diferencia con respecto al aislamiento T10 que tuvo menor crecimiento diametral del total de los aislamientos (Cuadro 1).
El crecimiento acelerado es característico de Trichoderma spp. lo que permite competir por espacio y nutrientes (Sánchez et al., 2015). Por lo tanto, la TC es una herramienta fisiológica útil para predecir la habilidad de biocontrol de nuevos aislamientos de Trichoderma spp. (Uzunovic y Webber, 1998).
Con respecto a la tasa de crecimiento de Colletotrichum, el aislamiento Z1 presentó valores significativamente diferentes (Tukey, 0.05) con respecto al aislamiento 108 y 112, puesto que el aislamiento Z1 cubrió la placa Petri de 9 cm de diámetro en siete días, en comparación con los aislamientos 108 y 112 que alcanzaron su máximo crecimiento hasta los 11 días después de la inoculación.
Identificación molecular. En el presente estudio, los productos obtenidos de la amplificación tuvieron un tamaño promedio de 620 pb (Figura 3A). Al comparar las secuencias con la base de datos del GeneBank, se determinó un porcentaje de identidad que oscilaron entre 98.62 y 99.99 % con las especies identificadas (Cuadro 1) como: Trichoderma harzianum (T7), T. spirale (T3, T9 y T10), T. lentiforme (T13, T14 y T15),
T. pleuroticola (T2), T. sulphureum (T4 y T5), T. tomentosum (T12) y T. koningii (T6).
T. koningii y T. harzianum se han reportado asociadas a sistemas agroforestales de café (Belayneh-Mulaw et al., 2010). Ahedo-Quero et al. (2024) señalan 57 especies de Trichoderma reportadas en México, de las cuales 12 corresponden al cultivo de café, siendo el cultivo con mayor diversidad. Sin embargo, en esta investigación T. lentiforme y T. sulphureum se reportan por primera vez en México en suelos cafetaleros con manejo orgánico.

Figura 3 Árbol filogenético. A) Productos de amplificación por PCR de la región ITS del ADNr con los oligonucleotidos universales ITS1 e ITS4 de aproximadamente 620 pb. B) Relación filogenética de 12 aislamientos de Trichoderma inferido por análisis de secuencias de ADNr (ITS1, 58S y ITS2). Los números en los nodos representan el porcentaje del bootstrapping con 1,000 repeticiones.
Los marcadores moleculares desempeñan un papel crucial en la identificación molecular de Trichoderma, en nuestros resultados la secuencia de los espaciadores internos transcritos (ITS) fueron adecuados para diferenciar los diferentes aislados de Trichoderma lo que coincide con otros estudios para esta región del rRNA (Islam et al., 2022). La topología del árbol filogenético fue generada empleando el método neighbor- joining con las secuencias de los aislamientos, se incluyó el número de accesión de la secuencia de referencia del GeneBank mayor al 98% de similitud. En el árbol generado se aprecian 7 grupos separados por especie (Figura 3B); además, se observa una relación intra específica en dos grupos predominantes con T. spirale (T3, T9 y T10) y T. lentiforme (T13, T14 y T15). Adicional al conocimiento de la diversidad de Trichoderma, este estudio es de interés por las aplicaciones biotecnológicas que puedan tener las cepas colectadas para el biocontrol de Colletotrichum sp.
La importancia del género Trichoderma como agente de control biológico implica mecanismos de acción como competencia por sustrato, micoparasitismo y antibiosis (Revilla-Medina et al., 2020; Rolz Asturias et al., 2013). Para la especie T. spirale, Baiyee et al. (2019) demostraron que su potencial como agente de biocontrol se debe a su competencia por espacio, los antifúngicos volátiles y las actividades enzimáticas. En un estudio reciente, Ye et al. (2023) indicaron que un compuesto extraído de T. spirale, tiene un fuerte efecto inhibidor sobre Candida albicans; por lo que la función de estos microorganismos no se limita al efecto en la salud y desarrollo de las plantas. Trichoderma koningii es una especie que gracias a su versatilidad funciona como biocontrol de fitopatógenos de suelos y foliares, obtenido entre un 70-100% de control bajo condiciones de invernadero (Nina et al., 2011).
La caracterización molecular mostró que los tres aislamientos de Colletotrichum corresponden a diferentes especies: C. gloeosporioides (Z1), C. siamense (108) y C. aenigma (112) (Figura 4). Dos (C. gloeosporioides y C. siamense) de estas tres especies identificadas en el presente estudio fueron previamente reportadas en el cultivo de café arábico como patógenas y afectando hojas y/o frutos (Cristobal-Martínez et al., 2016) en México; así como en Asia (Damm et al., 2012) y Brasil (Prihastuti et al., 2009). Mientras que C. aenigma, especie agrupada dentro del complejo C. gloeosporioides, no ha sido reportada en el cultivo de café arábico, por lo que podría considerarse el primer reporte de esta especie; sin embargo, debido a la complejidad para la identificación de especies de Colletotrichum, consideramos necesario realizar la caracterización molecular con el uso de secuencias multilocus adicionales a ITS (Cristobal-Martínez et al., 2016; Zhu et al., 2023) para aseverar la identificación de esta especie.
Pruebas de antagonismo. La inhibición del crecimiento micelial de Colletotrichum sp., se observó en su mayoría al cuarto día de incubación; corroborando el rápido crecimiento de Trichoderma y su potencial para inhibir el crecimiento micelial del fitopatógeno (Fernández y Suárez, 2009). El mayor porcentaje de inhibición del crecimiento miceliar de C. siamense (108) se observó al interaccionar con el aislamiento T15 de Trichoderma (Tukey, 0.05). En la interacción de las cepas de Trichoderma (T13, T14 y T15) con los aislamientos de C. gloeosporioides (Z1), C. siamense (108) y C. aenigma (112), se observó un cambio de color del medio de cultivo en la zona de interacción de los micelios de ambos microorganismos. Posteriormente las cepas de Trichoderma crecieron sobre el micelio de Colletotrichum; esta respuesta es un primer indicativo de su potencial como microorganismos hiperparásitos (Hernández-Mendoza et al., 2011).
La esporulación de Trichoderma sobre el micelio de Colletotrichum se observó solamente en la interacción T. lentiforme (T14) - C. siamense (108). La capacidad antagonista de Trichoderma para inhibir el crecimiento de Colletotrichum ha sido reportada de manera previa (Morales-Mora et al., 2020). En la Figura 5 se muestran las diferentes respuestas de inhibición del crecimiento miceliar de los aislamientos de Coletotrichum al evaluar nuestros aislamientos de Trichoderma. Esta inhibición del crecimiento se atribuye a la producción de metabolitos como quitinasas, glucanasas (Sánchez-García et al., 2017) y a la secreción de antibióticos u otras sustancias inhibidoras que producen las cepas antagónicas (Al-Mekhlafi et al., 2019).
Conclusiones
Se identificaron siete especies de Trichoderma: T. harzianum, T. spirale, T. lentiforme,
T. pleuroticola, T. sulphureum, T. tomentosum, y T. koningii, las cuales se distinguieron por su rápido desarrollo mostrando el característico color verde del género y presentando anillos concéntricos en algunos aislamientos. Cabe destacar el potencial de Trichoderma como biocontrolador sobre Colletotrichum actuando de diferentes maneras ante este fitopatógeno. Esto, aporta al conocimiento sobre la diversidad de Trichoderma nativos de la región cafetalera del estado de Oaxaca. Además, esta comprensión más profunda, contribuye a enriquecer el conocimiento y a elegir dichas especies para futuros estudios en el biocontrol de fitopatógenos, con el fin de promover prácticas agrícolas sostenibles.











 text in
text in